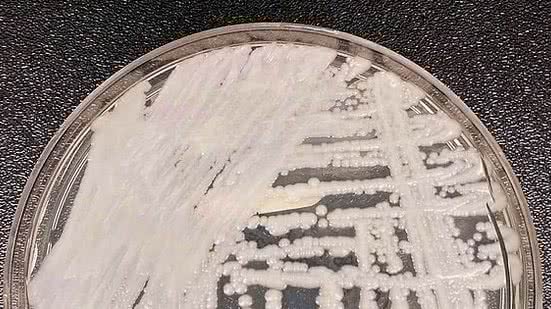

A Agência Nacional de Vigilância Sanitária (Anvisa) informou que foi notificada sobre a terceira infecção pelo fungo Candida auris. O caso foi diagnosticado em um hospital da cidade do Recife, em Pernambuco.
A Agência Nacional de Vigilância Sanitária (Anvisa) informou que foi notificada sobre a terceira infecção pelo fungo Candida auris. O caso foi diagnosticado em um hospital da cidade do Recife, em Pernambuco. O fungo foi identificado por análise do laboratório central Gonçalo Moniz, da Bahia.

LEIA TAMBÉM
Segundo a Anvisa, foram adotadas ações pelas autoridades de saúde para prevenção e combate à disseminação do organismo, como protocolos de segurança no hospital onde estava internado o paciente infectado.
A Coordenação Estadual de Prevenção e Controle de Infecção de Pernambuco realizou uma visita técnica ao hospital e conforme a Anvisa está monitorando o caso e as ações para controle de novas infecções.
Candida Auris - O organismo é chamado de superfungo pela resistência que possui a antibióticos e outras formas de tratamento. De acordo com a Anvisa, o fungo também permanece no ambiente por longos períodos, que podem chegar a meses, e resiste a diversos tipos de desinfetantes.
Por essas razões, casos de infecções pelo fungo trazem risco de surto e demandam monitoramento e medidas de prevenção e controle para impedir a disseminação em outros pacientes.
Conforme nota de alerta da agência, o Candida auris “pode causar infecção na corrente sanguínea e outras infecções invasivas, podendo ser fatal, principalmente em pacientes imunodeprimidos ou com comorbidades.”
O primeiro caso foi registrado em dezembro de 2020, da Bahia. Após ser notificada, a Anvisa emitiu uma nota de alerta destacando que o fungo significa uma ameaça à saúde global.